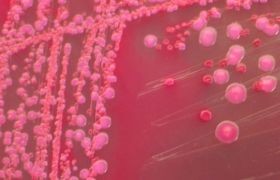
A cukor javíthatja az antibiotikus hatást?

A cukor javítja az antibiotikumok hatásfokát – állítják a Bostoni Egyetem kutatói.
A cukor javítja az antibiotikumok hatásfokát – állítják a Bostoni Egyetem kutatói.
A cukor javíthatja az antibiotikus hatást?
Forrás: Medipress
A megállapítás szerint a szőlőcukor és a gyümölcscukor fokozza a baktériumok antibiotikumokra való érzékenységét. Sok kórokozó ellenállási képességgel rendelkezik a gyógyszerekkel szemben, melyet úgy érnek el, hogy mintegy "hibernált" állapotba kerül. A túlélő baktérium aztán később újra aktiválódik, ami a betegség kiújulását eredményezi.
A Nature oldalain közölt vizsgálat megállapította, hogy a cukor lényegében "kihozza" a baktériumokat a hibernációból, ami ismét fogékonnyá teszi őket a kezeléssel szemben.
A módszert az Eschericia coli nevű baktériumon tesztelték, mely igen gyakran okoz pl. húgyúti fertőzéseket. A módszer segítségével a kutatók képesek volta kiirtani a kórokozók 99,9 százalékát, mintegy két órán belül. Ugyanakkor cukor nélkül a gyógyszer hatástalan volt.
A kutatók a jövőben a cukor tuberkulózisra gyakorolt hatását tervezik tesztelni.
Kövesse az Egészségkalauz cikkeit a Google Hírek-ben, a Facebook-on, az Instagramon vagy a X-en,Tiktok-on is!








